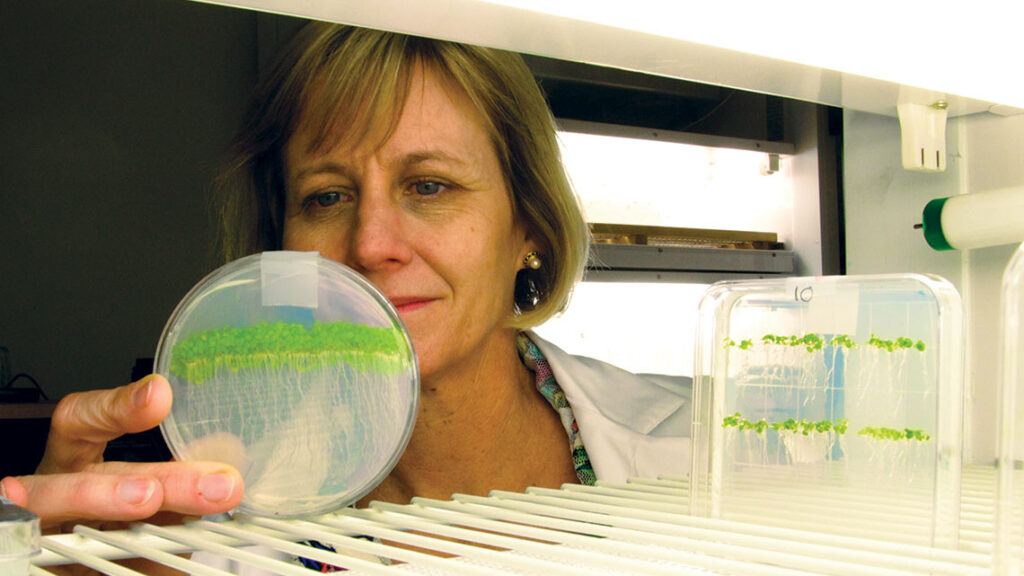
Julia Bailey-Serres,

VMek Group LLC – CSS ASTA From The Floor

Kent Lovvorn, VMek Group LLC talks about the Metrix Analytic System at ASTA CSS 2014 & Seed Expo.
IPSA Announces Leadership for 2015
Held in Tucson, Arizona, the Independent Professional Seed Association’s 26th Annual Conference is being reported as a tremendous success. “IPSA had larger attendance, more sponsorship support and more exhibitors than […]
Early Registration for Commodity Classic Ends Jan. 15
The deadline for saving on registration fees to the 20th Commodity Classic is approaching. Early bird registration ends Thursday, Jan. 15, for the event, which will be held in Phoenix, […]
IWYP Appoints Program Director
The International Wheat Yield Partnership, a funding and coordination partnership for stimulating wheat research and development to countries around the world has appointed Jeff Gwyn as director and will lead […]
Symbiota Names David Perry as New President and CEO
Symbiota has named David Perry as president and CEO to lead the company in its next phase of growth and commercialization. Symbiota is a pioneer of plant microbiome solutions that […]
AT Ferrell, From The Floor at ASTA CSS 2014 & Seed Expo

Cameron Clark, Design Engineer, AT Ferrell talks about the Clipper Control panel at ASTA CSS 2014 & Seed Expo
American Takii Breaks Ground on New Construction Project

American Takii recently held a groundbreaking ceremony to mark the start of construction of a new office building and state-of-the-art facility to allow for the expansion of seed processing, warehousing […]
Monsanto 2015 First Quarter Earnings Down
Monsanto Company has announced that gross profit for the 2015 first quarter decreased to $1.4 billion from the prior year. As previewed in the fourth quarter of fiscal year 2014, […]
BioAg Alliance Delivers Promising Field Trial Results
In its first full year of field trials, the BioAg Alliance — Novozymes’ and Monsanto’s collaboration to improve soil health and harvest through naturally-occurring microorganisms — reported that of the […]
Claudia Nari, Global Seed Regulatory Affairs Lead – CSS ASTA 2014 – Giant Views

Claudia Nari sits down with Issues Ink President Shawn Brook at ASTA’s CSS 2014 & Seed Expo in Chicago, Illinois December 8-12, 2014.
Antonio Tejada, Chair Seed Treatment Committee, SAA – CSS ASTA 2014 – Giant Views

Antonio Tejada sits down with Issues Ink President Shawn Brook at ASTA’s CSS 2014 & Seed Expo in Chicago, Illinois December 8-12, 2014.
Rurik B. Halaby, Chairman and Founder, AgriCapital – CSS ASTA 2014 – Giant Views

Rurik B. Halaby sits down with Issues Ink President Shawn Brook at ASTA’s CSS 2014 & Seed Expo in Chicago, Illinois December 8-12, 2014.
Mike Vande Logt, COO, Winfield Solutions – CSS ASTA 2014 – Giant Views

Mike Vande Logt sits down with Issues Ink President Shawn Brook at ASTA’s CSS 2014 & Seed Expo in Chicago, Illinois December 8-12, 2014.
Rolando Meninato, VP of Seeds, Dow AgroSciences – CSS ASTA 2014 – Giant Views

Rolando Meninato sits down with Issues Ink President Shawn Brook at ASTA’s CSS 2014 & Seed Expo in Chicago, Illinois December 8-12, 2014.
Todd Grimes, Business Development Manager, USC – CSS ASTA 2014 – Giant Views

Todd Grimes sits down with Issues Ink President Shawn Brook at ASTA’s CSS 2014 & Seed Expo in Chicago, Illinois December 8-12, 2014.
Alex Cochran – Director of R&D for the DuPont ST Enterprise – CSS ASTA 2014 – Giant Views

Alex Cochran sits down with Issues Ink President Shawn Brook at ASTA’s CSS 2014 & Seed Expo in Chicago, Illinois December 8-12, 2014.
Frank Terhorst, Global Head of Seeds, Bayer CropScience – CSS ASTA 2014 – Giant Views

Frank Terhorst sits down with Issues Ink President Shawn Brook at ASTA’s CSS 2014 & Seed Expo in Chicago, Illinois December 8-12, 2014.
Wheat Genome Sequencing Reaches New Milestone
The International Wheat Genome Sequencing Consortium (IWGSC) has completed high quality physical maps for six additional wheat chromosome arms. This achievement, part of a high quality reference sequence of the […]
Dan Custis, CEO, Advanced Biological Marketing – CSS ASTA 2014 – Giant Views

Dan Custis sits down with Issues Ink President Shawn Brook at ASTA’s CSS 2014 & Seed Expo in Chicago, Illinois December 8-12, 2014.
S&W Seed Company Promotes Staff
S&W Seed Company has appointed alfalfa industry veteran Kirk Rolfs as the company’s vice president of production. Rolfs will be responsible for contracting seed growers and management of the company’s […]
Garth Hodges, Business Development & Licensing, Bayer CropScience – CSS ASTA 2014 – Giant Views

Garth Hodges sits down with Issues Ink President Shawn Brook at ASTA’s CSS 2014 & Seed Expo in Chicago, Illinois December 8-12, 2014.
Manas Banerjee, President/CEO, Xitebio Technologies – CSS ASTA 2014 – Giant Views

Manas Banerjee sits down with Issues Ink President Shawn Brook at ASTA’s CSS 2014 & Seed Expo in Chicago, Illinois December 8-12, 2014.
Marcus Sheanshang, President and CEO JBM Envelope – CSS ASTA 2014 – Giant Views

Marcus Sheanshang sits down with Issues Ink President Shawn Brook at ASTA’s CSS 2014 & Seed Expo in Chicago, Illinois December 8-12, 2014.
Andy LaVigne, ASTA President and CEO – ASTA CSS 2014 – Giant Views

Andy LaVigne sits down with Issues Ink President Shawn Brook at ASTA’s CSS 2014 & Seed Expo in Chicago, Illinois December 8-12, 2014.
Bio-Safety Certificate for GM Phytase Corn Renewed
Origin Agritech, a technology-focused supplier of crop seeds in China, has received the renewed bio-safety certificate from the Ministry of Agriculture for its genetically modified phytase corn for the next […]
S&W Seed Closes Acquisition of DuPont Pioneer Alfalfa Assets
SW Global acquires DuPont Pioneer alfalfa assets, expanding its seed business. Get the details on the acquisition and its impact on the industry.
S&W Seed Closes Acquisition of DuPont Pioneer Alfalfa Assets
S&W Seed Company closed the acquisition of DuPont Pioneer’s alfalfa production and research facility assets, as well as conventional alfalfa germplasm. “We are extremely pleased to have completed the acquisition of DuPont […]
K-State Researchers Work to Develop Heat-tolerant Wheat
Harold Trick, a Kansas State University plant pathologist, and Allan Fritz, a KSU wheat breeder, are working on a transgenic wheat that tolerates warmer temperatures during wheat’s critical grain filling […]
Seed Companies Talk Priorities for 2015

Goals and priorities provide direction and help lead to success. A Note from the Editor This time of the year, there’s always a great deal of chatter about new year’s […]
Highlights from ASTA’s Corn, Sorghum and Soybean Seed Research Conference

Each year, the American Seed Trade Association hosts its corn, sorghum and soybean seed research conference. In case you missed it, here are a few of the highlights. Nearly 3,000 […]
Researchers Work to Waterproof Rice
What researchers learn from a specific rice gene could one day help to reduce crop damage from flooding that occurs after planting. Understanding the genetics of various seed characteristics can […]
Can We Build a Better Bee?

Can we build a better bee that is designed to withstand stressors, such as the Varroa mite, American foulbrood, Nosema ceranae and even extreme weather conditions, through genetics? In many […]
Nufarm U.S. Promotes Staff

Nufarm U.S. has promoted Rob Schwehr to the position of vice president of innovation and regulatory affairs for Nufarm Americas. Schwehr will oversee product development and interactions with governmental agencies […]
Expanding into International Markets? Culture Is Key to Success

When it comes to expanding in international markets, experience and a good business plan can mean the difference between failure and success. Expanding into a market outside your country’s borders […]
Independent Seed Companies are Thriving

Regional, independent seed companies are thriving. Mark Twain is quoted as having said “the rumors of my death have been greatly exaggerated.” Rapid consolidation in the seed industry during the […]
Secrets of the 100 Most Innovative People

While it’s critical to look ahead, it’s also important to remember our history and reflect upon the progress that’s been made. Discover the faces behind that progress and today’s seed […]
